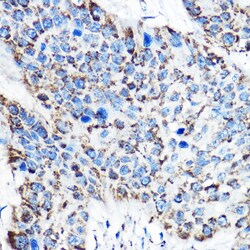
Invitrogen OAT Polyclonal Antibody 100 &mu;L | Buy Online | Invitrogen&trade; | Fisher Scientific

Learn More
Invitrogen™ OAT Polyclonal Antibody


Description
Immunogen sequence: VKGIQKYKAK IVFAAGNFWG RTLSAISSST DPTSYDGFGP FMPGFDIIPY NDLPALERAL QDPNVAAFMV EPIQGEAGVV VPDPGYLMGV RELCTRHQVL FIADEIQTGL ARTGRWLAVD YENVRPDIVL LGKALSGGLY PVSAVLCDDD IMLTIKPGEH GSTYGGNPLG CRVAIAALEV LEEENLAENA DKLGIILRNE LMKLPSDVVT AVRGKGLLNA IVIKETKDWD AWKVCLRLRD NGLLAKPTHG DIIRFAPPLV IKEDELRESI EIINKTILSF; Positive Samples: SW480, MCF7, 293T, A-549, HepG2, Mouse liver, Mouse lung, Mouse kidney, Rat kidney; Cellular Location: Mitochondrion matrix.

Specifications
Specifications
| Antigen | OAT |
| Applications | ELISA, Immunohistochemistry (Paraffin), Immunoprecipitation, Western Blot |
| Classification | Polyclonal |
| Concentration | 2.64 mg/mL |
| Conjugate | Unconjugated |
| Formulation | PBS with 50% glycerol and 0.02% sodium azide; pH 7.3 |
| Gene | OAT |
| Gene Accession No. | P04181, P04182, P29758 |
| Gene Alias | AI194874; GACR; gyrate atrophy; HOGA; OAT; OATASE; OKT; ornithine aminotransferase; ornithine aminotransferase (gyrate atrophy); Ornithine aminotransferase, hepatic form; Ornithine aminotransferase, mitochondrial; Ornithine aminotransferase, renal form; Ornithine delta-aminotransferase; ornithine-delta-aminotransferase; ornithine--oxo-acid aminotransferase; ornithine-oxo-acid aminotransferase; rOAT; testicular tissue protein Li 130 |
| Gene Symbols | OAT |
| Show More |
Safety and Handling
By clicking Submit, you acknowledge that you may be contacted by Fisher Scientific in regards to the feedback you have provided in this form. We will not share your information for any other purposes. All contact information provided shall also be maintained in accordance with our Privacy Policy.